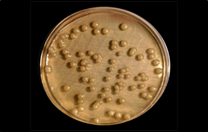
Sacharomyces cerevisiae, levadura del pan, cerveza, vino…
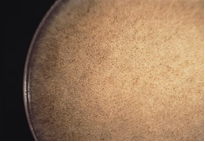
Rhizopus stolonifer, primitivo moho del pan
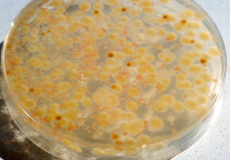
Flora mixta de levaduras y mohos, vista desde abajo.

sabouraud-dextrose-cloranfenicol-agar, el medio más clásico para contar hongos (levaduras y mohos) en alimentos, cosméticos, medicamentos…
Recuento selectivo de Levaduras y Mohos UNE 34 821:1986 e ISOS cosméticas: NF T75-611 (Poder inhibitorio intrínseco), ISO 16212 (recuento de hongos), ISO 18416 (Candida albicans).
COMPOSICIÓN
- Polipeptona micológica 10,00 g
- Dextrosa 40,00g
- Cloranfenicol 0,50g (provoca la etiqueta de riesgo, pero menor cantidad no es efectiva)
- Agar‑agar 15,00g
(Fórmula por litro)
pH final: 5,6 ± 0,2
PREPARACIÓN
Disolver 65,5 g de medio en 1 litro de agua destilada. Calentar hasta ebullición, agitando para su completa disolución. Repartir en tubos o frascos. Autoclavar a 121 ºC durante 15 minutos, o mejor 116 ºC durante 10 minutos evitando el sobrecalentamiento.
PARA USO EXCLUSIVO EN LABORATORIO. MANTENGA EL BOTE BIEN CERRADO EN LUGAR SECO, FRESCO Y OSCURO. AGITE EL BOTE ANTES DE USAR.
DESHIDRATADO CODIGO: DMT102
CONTROL DE CALIDAD DEL MEDIO
Realizado en nuestro laboratorio; es prudente repetirlo en su laboratorio siempre que varíen las condiciones (más de 3 meses sin usar, tras desinfectar laboratorio, tras conservar a alta Tª, cuando adquiere aspectos extraños aunque no haya llegado la fecha de caducidad teórica de la etiqueta,…)
DESHIDRATADO: Polvo grueso, Crema PREPARADO: Estéril, Crema
CONTROL DE CRECIMIENTO CUANTITATIVO 3-5 días a temperatura ambiente (21-28°C aproximadamente):
- Staphylococcus aureus MKTA 6538P, Inhibido.
- E.coli MKTA 25922, Inhibido.
- Aspergillus niger MKTA 16404, Correcto, Colonias negras y esporuladas en 5 días. Con respecto a PCA estandarizado*, recuento 73-475 %, pero de forma selectiva.
- Saccharomyces cerevisiae MKTA 9763, Correcto. Con respecto a PCA estandarizado*, recuento 95-170 %, pero de forma selectiva.
- Candida albicans MKTA 10231, Excelente. Con respecto a PCA estandarizado*, recuento medio 122-144 %, pero de forma selectiva.
* El que cumple con recuperación superior al 92-125% con respecto a cepas cuantitativas trazables a la cepa tipo. Incertidumbres detectadas entre todos los lotes a lo largo de un año (la mayoría de la incertidumbre se debe a la cepa y a la proporción de cepas acompañantes inoculadas, no al medio).
PRESENTACIÓN: TUBOS 20 ml, FRASCOS 100 y 250 ml, MEDIO DESHIDRATADO, DESINFECTEST-LM, PLAQUITAS HERMETICAS MF
NOTA: Medio de uso muy extendido para el aislamiento y recuento de hongos (levaduras y mohos) en la industria alimentaria. Es más útil para cultivo rápido que para recuento (para éste es mejor el Rosa Bengala CAF Agar).
El cloranfenicol actúa como antibacteriano termoestable de amplio espectro, lo que da al medio una excelente selectividad con respecto al Sabouraud Dextrose Agar. El medio se incuba a 20-25 ºC aproximadamente, durante 3-5 días.
SIEMBRA
Con los tubos 20 ml y los frascos se preparan placas. En éstas se siembra en superficie, extendiendo con un triángulo de vidrio flameado.
INTERPRETACIÓN
Las levaduras aparecen como colonias no filamentosas, a menudo mucosas. Los mohos crecen con colonias filamentosas y de margen difuso. Identificar al microscopio los mohos y con YEAST-IDENT las levaduras.
https://www.microkit.es/fichas/SABOURAUD-DEXTROSE-CAF-AGAR.pdf
El usuario final es el único responsable de la destrucción de los organismos que se hayan desarrollado, según la legislación medioambiental vigente.
sabouraud-dextrose-cloranfenicol-agar, el medio más clásico para contar hongos (levaduras y mohos) en alimentos, cosméticos, medicamentos…
Si desea más información sobre nuestros SABOURAUD DEXTROSE CAF (CLORANFENICOL) AGAR rellene nuestro formulario de contacto http://www.medioscultivo.com/contacto . O si lo prefiere póngase en contacto con nosotros a través de nuestro correo electrónico microkit@microkit.es o por teléfono en el nº 91-897 46 16
NUEVO: Sabouraud Rapid YM Agar. Los hongos (levaduras y mohos) han sido hasta ahora el eslabón más débil de la cadena del análisis microbiológico, al tardar 3-5 días en obtener resultados fiables. MICROKIT ha inventado durante la pandemia de 2020, el medio de cultivo del siglo XXI para detección y recuento rápidos (18-48h) y fiables (ver validaciones internas) de estos microorganismos. En 18 horas ya hay viraje de color del medio (de violeta a amarillo) de las levaduras y mohos que en las próximas horas crecerán en forma de colonias típicas; y en 48 horas ya han crecido todas las colonias típicas que en Sabouraud clásico y demás medios habituales, tardan hasta 5 días en crecer. Minimice sus stocks de producto terminado en cuarentena, gracias a Rapid YM Agar de MICROKIT.
https://www.microkit.es/monograficos/4-Levaduras-y-mohos-monograf–a.pdf